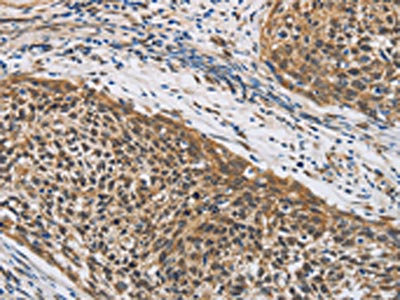

LEF1 Antibody
-
中文名稱:LEF1兔多克隆抗體
-
貨號:CSB-PA069370
-
規格:¥1100
-
圖片:
-
The image on the left is immunohistochemistry of paraffin-embedded Human cervical cancer tissue using CSB-PA069370(LEF1 Antibody) at dilution 1/20, on the right is treated with fusion protein. (Original magnification: ×200)
-
The image on the left is immunohistochemistry of paraffin-embedded Human tonsil tissue using CSB-PA069370(LEF1 Antibody) at dilution 1/20, on the right is treated with fusion protein. (Original magnification: ×200)
-
-
其他:
產品詳情
-
Uniprot No.:
-
基因名:
-
別名:DKFZp586H0919 antibody; FLJ46390 antibody; LEF 1 antibody; LEF-1 antibody; Lef1 antibody; LEF1_HUMAN antibody; Lymphoid enhancer binding factor 1 antibody; Lymphoid enhancer-binding factor 1 antibody; T cell specific transcription factor 1 alpha antibody; T cell-specific transcription factor 1-alpha antibody; TCF 1 alpha antibody; TCF1 alpha antibody; TCF1-alpha antibody; TCF10 antibody; TCF1alpha antibody; TCF7L3 antibody; Transcription factor T cell specific 1 alpha antibody
-
宿主:Rabbit
-
反應種屬:Human,Mouse,Rat
-
免疫原:Fusion protein of Human LEF1
-
免疫原種屬:Homo sapiens (Human)
-
標記方式:Non-conjugated
-
抗體亞型:IgG
-
純化方式:Antigen affinity purification
-
濃度:It differs from different batches. Please contact us to confirm it.
-
保存緩沖液:-20°C, pH7.4 PBS, 0.05% NaN3, 40% Glycerol
-
產品提供形式:Liquid
-
應用范圍:ELISA,IHC
-
推薦稀釋比:
Application Recommended Dilution ELISA 1:1000-1:2000 IHC 1:25-1:100 -
Protocols:
-
儲存條件:Upon receipt, store at -20°C or -80°C. Avoid repeated freeze.
-
貨期:Basically, we can dispatch the products out in 1-3 working days after receiving your orders. Delivery time maybe differs from different purchasing way or location, please kindly consult your local distributors for specific delivery time.
-
用途:For Research Use Only. Not for use in diagnostic or therapeutic procedures.
相關產品
靶點詳情
-
功能:Transcription factor that binds DNA in a sequence-specific manner. Participates in the Wnt signaling pathway. Activates transcription of target genes in the presence of CTNNB1 and EP300. PIAG antagonizes both Wnt-dependent and Wnt-independent activation by LEF1. TLE1, TLE2, TLE3 and TLE4 repress transactivation mediated by LEF1 and CTNNB1. Regulates T-cell receptor alpha enhancer function. Required for IL17A expressing gamma-delta T-cell maturation and development, via binding to regulator loci of BLK to modulate expression. May play a role in hair cell differentiation and follicle morphogenesis.; Transcriptionally activates MYC and CCND1 expression and enhances proliferation of pancreatic tumor cells.; Lacks the CTNNB1 interaction domain and may therefore be an antagonist for Wnt signaling.; Transcriptionally activates the fibronectin promoter, binds to and represses transcription from the E-cadherin promoter in a CTNNB1-independent manner, and is involved in reducing cellular aggregation and increasing cell migration of pancreatic cancer cells.
-
基因功能參考文獻:
- Experimental analysis showed the importance of LEF1, ETV4 and FABP6 as three co-regulated prognostic markers in patients with colorectal cancer metastasis. PMID: 30193961
- LEF-1 and CDX2 performed at least as well as beta-catenin, if not better, as a diagnostic marker for pilomatrical carcinomas PMID: 29369390
- study identifies a novel mechanism of hepatocellular carcinoma inhibition through beta-catenin-independent Wnt signalling, which is regulated by WT1-associated LEF1 repression. The study also highlights mangiferin as a promising Wnt inhibitor for HCC treatment. PMID: 29953980
- High LEF1 expression is associated with papillary thyroid carcinoma. PMID: 28677753
- LEF1 was consistently expressed in the tubal-peritoneal junctions and all tubal intraepithelial lesions, independent of p53 status. PMID: 28664938
- these data suggest that LEF1 rather has tumor suppressive functions and attenuates aggressiveness in a subset of RMS. PMID: 27965462
- Positive LEF-1 favors a benign neoplasm. PMID: 28972308
- Results show that high enhancer-binding factor-1 (LEF1) expression is associated with poor survival for chronic lymphocytic leukemia (CLL) patients. PMID: 26950276
- Knockdown of GATA6 completely eliminated the effect of TCF1, while forced expression of GATA6 induced hESC differentiation PMID: 28943339
- Lef1 and Tcf1 showed oncogenic effect in colonic carcinogenesis. Cellular context of miRNAs might play important roles in carcinogenesis by altering the expression pattern of Lef/Tcfs members. PMID: 27433921
- Data indicate that microRNA miR-27a directly targets GSK-3beta and increases expression of beta-catenin and LEF1 in all-trans-retinoic acid (ATRA)-induced Hep2 cells. PMID: 28122350
- and CTU1/2, partner enzymes in U34 methoxycarbonylmethyl-2-thio tRNA modification, are up-regulated in human breast cancers and sustain metastasis. PMID: 27811057
- MicroRNA-557 might work as a tumor suppressor by negatively regulating the expression of lymphocyte enhancement factor 1 in lung cancer cells. PMID: 28639890
- EVI1 transcription is directly regulated by LEF1/beta-catenin complex in myeloid blast crisis of chronic myeloid leukemia. Loss of p53 function as a key regulator for beta-catenin-EVI1 in myeloid blast crisis of chronic myeloid leukemia. PMID: 27908728
- LEF1 is a sensitive and specific marker for chronic lymphocytic B-cell leukemia PMID: 28395058
- a frequency of 4-9% expression of LEF1 bymantle cell lymphoma PMID: 28038713
- The results suggest a role for beta-catenin/LEF1-mediated transcription in both malignant transformation and metastasis of prostate cancer PMID: 27067790
- The results describe a novel mutation in LEF1 causing dysregulation of Wnt/B catenin signaling in eyelid sebaceous cancinoma PMID: 25639559
- LEF-1 and MITF regulate tyrosinase gene transcription in vitro via binding to its promoter. PMID: 26580798
- Methylprednisolone can suppress Wnt signaling pathway by down-regulating LEF-1 protein expression in chronic lymphocyte leukemia cells. PMID: 26339357
- Overexpression of LEF1 is a favorable prognostic factor in childhood ALL. PMID: 25955539
- Authors found that the N-terminus of delta-catenin bound to the middle region of LEF-1 unlike beta-catenin. Overexpressed delta-catenin entered the nucleus and inhibited LEF-1-mediated transcriptional activity in Bosc23 and DLD-1 cell lines. PMID: 25808920
- high LEF1 expression and mutation are associated with high-risk leukemia and our results also revealed that LEF1 high expression and/or gain-of-function mutations are involved in leukemogenesis of ALL. PMID: 25942645
- Study found a negative correlation between miR-34a and LEF1 expression in prostate cancer cell lines and tumors and that miR-34a regulated epithelial-mesenchymal transition through direct binding to LEF1 mRNA 3' UTR region and silencing its translation. PMID: 25587085
- Our study suggests LEF1 expression in oral squamous cell carcinoma may play an important role in tumor progression and can be served as a predictor of poor prognosis for patients with oral squamous cell carcinoma. PMID: 24021930
- Elevated TCF-1 and LEF-1 expression is characteristic of malignant gliomas PMID: 24858819
- LEF-1 expression is associated with the presence of KRAS mutations and may have prognostic value as a trend of worse overall survival is seen in patients with LEF-1-positive colorectal carcinoma. PMID: 25394300
- These results further implicate the CTNNB1/LEF1 transcriptional complex in the development of solid-pseudopapillary neoplasms of the pancreas PMID: 24658583
- study identified TCF1 and LEF1 as Tax antagonistic factors in vivo, a fact which may critically influence the peripheral T-cell tropism of this virus PMID: 25646419
- miR26b may act as a potential therapeutic agent in reducing cancer cell proliferation through repressing LEF1 activation of c-Myc and cyclin D1 expression PMID: 24785257
- Tcf1 and Lef1 cooperate with Runx factors to achieve stable silencing of the Cd4 gene in CD8(+) T cells. PMID: 24847765
- LEF-1 expression in both basal cell adenomas and basal cell adenocarcinomas preferentially over other salivary gland tumors suggesting some utility as a diagnostic marker PMID: 25497834
- Proper sample processing ensured sufficient separation of positive LEF1 staining in T cells from negative staining in normal B and natural killer (NK) cells PMID: 25596247
- LEF1 expression is an independent prognostic factor in APL, and could be used in patients risk stratification. PMID: 24378360
- Selenite caused CYLD upregulation via LEF1 and cIAP downregulation, both of which contribute to the degradation of ubiquitin chains on RIP1 and subsequent caspase-8 activation and colorectal tumor cell apoptosis. PMID: 24577083
- Results indicate that lymphoid enhancer-binding factor 1 (LEF1) contributes to the pathophysiology of acute myeloid leukemia (AML) and could be a predictor of better treatment response. PMID: 23713453
- the expression of LEF1 is associated with the progression of human renal cell carcinoma and LEF1 maybe involved in the development of RCC PMID: 24897388
- By beta-catenin's association with LEF1 and BCL9-2/B9L. PMID: 24419084
- LEF1 protein was overexpressed in colon cancer tissues and knockdown of LEF1 expression inhibited colon cancer growth in vitro and in vivo. PMID: 24098538
- Studied the expression of TCF/LEF and SFRP family members (SFRP1 and SFRP3) to gain a better understanding of biological signaling pathways responsible for epidemiology and clinical parameters of clear cell RCC (cRCC). PMID: 23572277
- High LEF1 expression is associated with prostate cancer. PMID: 23913826
- DNA-dependent protein kinase catalytic subunit is a novel interaction partner of lymphocyte enhancer factor 1. PMID: 23325550
- This study supports a functionally important role for LEF1 and its target genes in Burkitt's lymphoma. PMID: 23375451
- this study demonstrated that miR-449a directly targets LEF-1, which in turn affects the expression of Sox 9, ultimately leading to the proper regulation of the differentiation and chondrogenesis PMID: 22769578
- Nuclear LEF1 correlate with cerebral metastasis of lung adenocarcinomas. PMID: 23224985
- LEF-1 might play an important role in colon carcinogenesis by acting as a regulator. PMID: 22639890
- Lef1 is overexpressed in human endometrial tumors, consistent with it playing a role in gland proliferation. PMID: 22792274
- An association between the maternal genotype and the occurrence of cleft lip or palate was observed at two polymorphic loci (rs10022956 and rs10025431), while a foetal-maternal effect modulating the risk of clefting was found at locus rs10025431. PMID: 21781440
- n-Butyl benzyl phthalate promotes breast cancer progression by inducing expression of lymphoid enhancer factor 1 PMID: 22905168
- interaction of HCLS1 with LEF-1 is essential for G-CSF-triggered myeloid differentiation PMID: 23001182
顯示更多
收起更多
-
亞細胞定位:Nucleus.
-
蛋白家族:TCF/LEF family
-
組織特異性:Detected in thymus. Not detected in normal colon, but highly expressed in colon cancer biopsies and colon cancer cell lines. Expressed in several pancreatic tumors and weakly expressed in normal pancreatic tissue. Isoforms 1 and 5 are detected in several
-
數據庫鏈接:
Most popular with customers
-
-
YWHAB Recombinant Monoclonal Antibody
Applications: ELISA, WB, IHC, IF, FC
Species Reactivity: Human, Mouse, Rat
-
Phospho-YAP1 (S127) Recombinant Monoclonal Antibody
Applications: ELISA, WB, IHC
Species Reactivity: Human
-
-
-
-
-